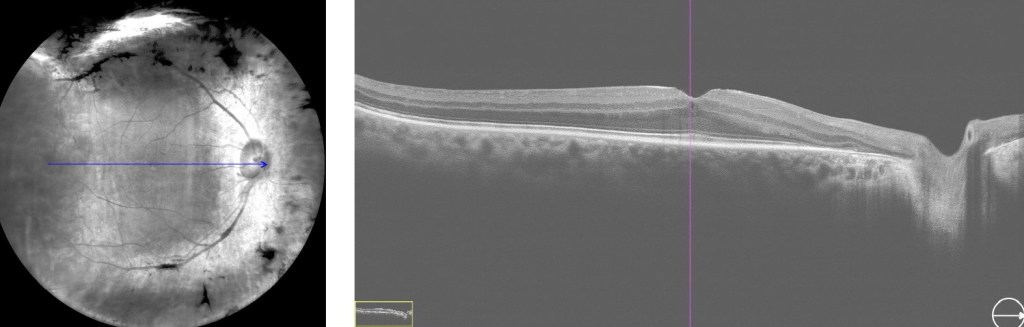
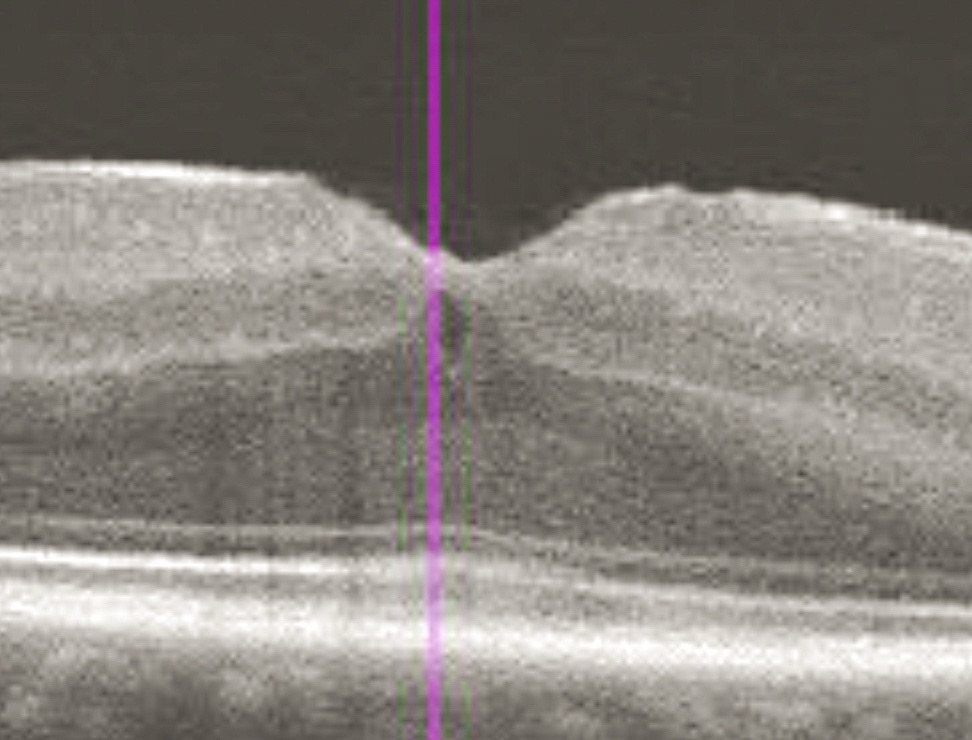

Chers lecteurs,
Je souhaite vous partager un cas très intéressant de chirurgie chez un patient atteint de rétinopathie diabétique sévère. Un homme de 63 ans, diabétique, présentait une cataracte modérée et une baisse progressive de la vision, réduite à la perception des doigts. Malgré un traitement clinique antérieur, la maladie avait continué de progresser. Il avait été soumis à des examens du fond d’œil, à une angiographie à la fluorescéine et à une tomographie par cohérence optique.
La procédure a débuté par l’extraction de la cataracte, suivie d’une vitrectomie standard par pars plana, réalisée à travers trois orifices avec un calibre de 23. Une prolifération fibrovasculaire dense a été observée au niveau de la zone maculaire. Une pince crantée de calibre 25 a été utilisée pour engager et soulever le tissu fibreux, qui a été pelé en bloc. Deux échanges air-fluide ont été effectués au cours de l’intervention.
Je recommande vivement une chirurgie précoce afin d’éviter les complications rétiniennes, comme dans ce cas.
Merci pour votre attention, Dr. Hudson Nakamura
Chirurgie de la rétine par le Dr Hudson Nakamura | Dévoiler la macula dans la rétinopathie diabétique sévère | https://youtu.be/ZMcXglC1j5A
(Lien Chaîne YouTube Retinawesome) |
📊Regardez notre série 3D et apprenez ! COMMENT synchroniser – EyeTube Sync Videos 3D : https://eyetube.net/channels/retina-3d |
✍️Visitez notre page Web à https://https://www.retinawesome.online |
🔜Suivez Retinawesome Retina & Vitreous International (YouTube) : https://youtube.com/c/retinawesomeretinavitreousinternational |
📖Rejoignez-nous : https://linktr.ee/drhudsonnakamura
••• D’autres chirurgies:
https://youtu.be/bnusAxPP2ag (Lien YouTube)